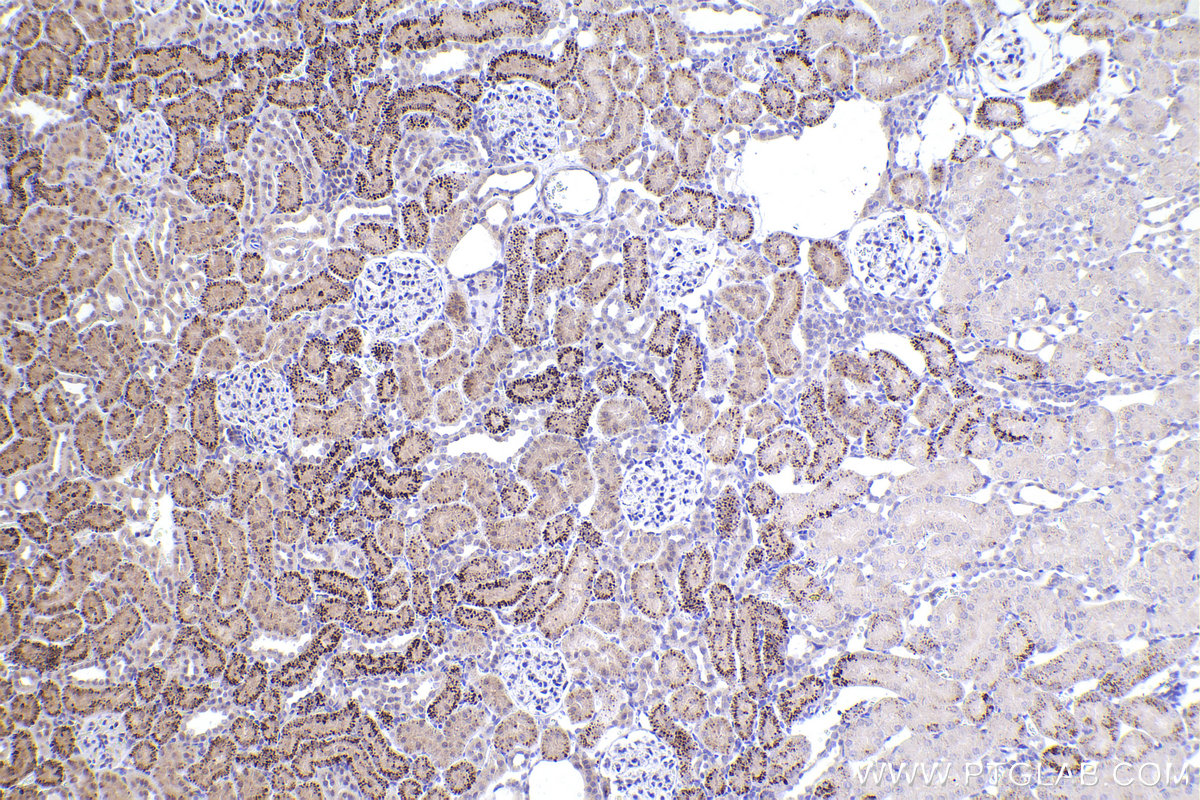

验证数据展示
经过测试的应用
| Positive WB detected in | ROS1728 cells, MCF-7 cells |
| Positive IP detected in | ROS1728 cells |
| Positive IHC detected in | rat skin tissue, rat kidney tissue Note: suggested antigen retrieval with TE buffer pH 9.0; (*) Alternatively, antigen retrieval may be performed with citrate buffer pH 6.0 |
| Positive IF/ICC detected in | ROS1728 cells |
| Positive FC (Intra) detected in | HepG2 cells |
推荐稀释比
| 应用 | 推荐稀释比 |
|---|---|
| Western Blot (WB) | WB : 1:200-1:1000 |
| Immunoprecipitation (IP) | IP : 0.5-4.0 ug for 1.0-3.0 mg of total protein lysate |
| Immunohistochemistry (IHC) | IHC : 1:250-1:1000 |
| Immunofluorescence (IF)/ICC | IF/ICC : 1:200-1:800 |
| Flow Cytometry (FC) (INTRA) | FC (INTRA) : 0.40 ug per 10^6 cells in a 100 µl suspension |
| It is recommended that this reagent should be titrated in each testing system to obtain optimal results. | |
| Sample-dependent, Check data in validation data gallery. | |
产品信息
20700-1-AP targets RUNX2 in WB, IHC, IF/ICC, FC (Intra), IP, chIP, ELISA applications and shows reactivity with human, rat samples.
| 经测试应用 | WB, IHC, IF/ICC, FC (Intra), IP, ELISA Application Description |
| 文献引用应用 | WB, IHC, IF, IP, chIP |
| 经测试反应性 | human, rat |
| 文献引用反应性 | human, mouse, rat, pig, rabbit, chicken |
| 免疫原 |
Peptide 种属同源性预测 |
| 宿主/亚型 | Rabbit / IgG |
| 抗体类别 | Polyclonal |
| 产品类型 | Antibody |
| 全称 | runt-related transcription factor 2 |
| 别名 | AML3, AML-3, CBF-alpha-1, Core-binding factor subunit alpha-1, OSF 2 |
| 计算分子量 | 57 kDa |
| 观测分子量 | 57-60 kDa |
| GenBank蛋白编号 | NM_004348 |
| 基因名称 | RUNX2 |
| Gene ID (NCBI) | 860 |
| RRID | AB_2722783 |
| 偶联类型 | Unconjugated |
| 形式 | Liquid |
| 纯化方式 | Antigen affinity purification |
| UNIPROT ID | Q13950 |
| 储存缓冲液 | PBS with 0.02% sodium azide and 50% glycerol, pH 7.3. |
| 储存条件 | Store at -20°C. Stable for one year after shipment. Aliquoting is unnecessary for -20oC storage. |
背景介绍
RUNX2, also named as AML3, CBFA1, OSF2 and PEBP2A, is a Transcription factor which involved in osteoblastic differentiation and skeletal morphogenesis. It is essential for the maturation of osteoblasts and both intramembranous and endochondral ossification. CBF binds to the core site, 5'-PYGPYGGT-3', of a number of enhancers and promoters, including murine leukemia virus, polyomavirus enhancer, T-cell receptor enhancers, osteocalcin, osteopontin, bone sialoprotein, alpha 1(I) collagen, LCK, IL-3 and GM-CSF promoters By similarity. RUNX2 inhibits MYST4-dependent transcriptional activation. The antibody is specific to RUNX2.
实验方案
| Product Specific Protocols | |
|---|---|
| FC protocol for RUNX2 antibody 20700-1-AP | Download protocol |
| IF protocol for RUNX2 antibody 20700-1-AP | Download protocol |
| IHC protocol for RUNX2 antibody 20700-1-AP | Download protocol |
| IP protocol for RUNX2 antibody 20700-1-AP | Download protocol |
| WB protocol for RUNX2 antibody 20700-1-AP | Download protocol |
| Standard Protocols | |
|---|---|
| Click here to view our Standard Protocols |
发表文章
| Species | Application | Title |
|---|---|---|
Bioact Mater 3D Printed Biomimetic Metamaterials with Graded Porosity and Tapering Topology for Improved Cell Seeding and Bone Regeneration | ||
Small Honeycomb Bionic Graphene Oxide Quantum Dot/Layered Double Hydroxide Composite Nanocoating Promotes Osteoporotic Bone Regeneration via Activating Mitophagy | ||
Sci Adv Multiomic identification of senescent stem cell populations critical for osteoarthritis progression and therapy in subchondral bones | ||
Redox Biol Endogenous hydrogen sulfide accelerated trauma-induced heterotopic ossification through the Ca2+/ERK pathway-enhanced aberrant osteogenic activity | ||
Mater Today Bio Sustained release of naringin from silk-fibroin-nanohydroxyapatite scaffold for the enhancement of bone regeneration. | ||
Mater Today Bio A biomimetic multimodal nanoplatform combining neutrophil-coated two-dimensional metalloporphyrinic framework nanosheet and exendin-4 to treat obesity-related osteoporosis |